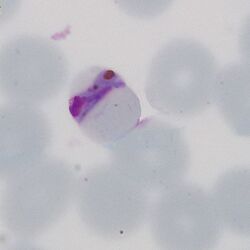

Plasmodium malariae: Morphology: Difference between revisions
From MalariaETC
No edit summary |
No edit summary |
||
| Line 37: | Line 37: | ||
<gallery mode="nolines" widths=250px heights=250px> | <gallery mode="nolines" widths=250px heights=250px> | ||
File:PMLTc.jpg|link={{filepath:PMLTc.jpg}} | File:PMLTc.jpg|link={{filepath:PMLTc.jpg}} | ||
File: | File:PMLT2.jpg|link={{filepath:PMLT2.jpg}} | ||
</gallery> | </gallery> | ||
<br clear=all> | <br clear=all> | ||
Revision as of 22:37, 17 December 2024
| Navigation |
| >Main malaria Index |
| >Main Species identification page |
Morphology of Plasmodium malariae
(See Malaria Biology pages for an explanation of these stages)
The early trophozoite
During this later growth stage the rings enlarge and begin to modify the erythrocyte, forming typical features of the species.
- Generally large rings forms, red cells not usually multiply infected
- Red cells begin to enlarge and may have ovoid or fimbriated apearance
- James' dots (morphologically indistinguishable from Schüffner's dots) begin to appear
- Pigment will not generally be detected at the early trophozoite stage
The late trophozoite
As parasites grow but generally retain their general ring shape, maturation is accompanied by clear modification of red cells to become ovoid and/or fimbriated; metabolism of haemoglobin causes malaria pigment to form.
- Parasites become larger and thickened, although the ring form is generally retained
- Red cell enlargement may lead to the ovoid fimbriated form often described as "comet forms"
- James' dots will now be prominent in appropriately stained specimens
- Pigment will now be seen over the surface of the parasite
The schizont
The asexual schizont stage of development will often be identified in the blood of this species, while smaller than P.vivax, species-specific features may not be clearly seen.
- A range of "schizont forms" will generally be present within moderately enlarged red cells
- When mature schizonts may contain 16-24 separate merozoites
- James' dots may be detected in any residual cytoplasm of the erythrocyte
- Pigment will be visible in irregularly distributed clumps
The gametocyte
The sexual replication form resembles P.vivax although generally smaller with sme species-specific forms detectable.
- Red cells will generally enlarged and may have ovoid or fimbriated form
- Macrogametocytes (female form) will often entirely fill the erythrocyte
- Microgametocytes (male form) have a cytoplasmic rim with visible James' dots
- Pigment is clumped evenly over the surface of the gametocyte